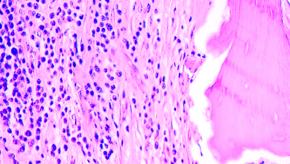
osteomyelitis%20chronic%20type%20micro.jpg

All News
High Lupus Flare and Complication Rates in Lupus Pregnancy
An incident cohort study from Denmark showed that 84 SLE pregnancies resulted in 62 live births. Lupus disease activity strongly influenced maternal complications seen in half and fetal complications were observed in one-third of cases.
Read ArticleConservative Equals Surgical Management of Lumbar Spinal Stenosis
A randomized controlled trial of compared the outcomes of surgical decompression or physical therapy in 169 lumbar spinal stenosis patients. After two years, intention-to-treat analyses revealed no difference between groups.
Read ArticlePsoriatic Arthritis Occurs in 10-15% of Psoriasis Patients
Estimates on the prevalence of psoriatic arthritis among psoriasis patients has varied widely, ranging from 5-40%. A systematic review of the literature shows that prevalence of undiagnosed PsA was 15.5% when all studies were considered and 10.1% when only epidemiological studies were consi
Read ArticleBrain Natriuretic Peptide Measurement in Rheumatoid Arthritis
Cardiovascular (CV) risk and adverse cardiac outcomes are common in rheumatoid arthritis (RA). It has been presumed that chronic systemic inflammation has a deleterious effect on the myocardium and vasculature, thereby leading to higher rates of MI, CHF and CV death.
Read ArticleIntraarticular Hip Injection of Ketorolac Equals Steroid Responses
Using ultrasound guided intraarticular injection of the hip, 98 OA of the hip patients were randomized to receive IA ketorolac or triamcinolone. At, 1, 3, and 6 mos pain scale and Harris hip scores were improved equally in both groups with no statistical differences.
Read Article
Thiazide Diuretics May Reduce Osteoporotic Fracture Risk
A large Swedish cohort study of hypertensive men and women presented at the 25th Scientific Meeting of the European Society of Hypertension, identitied a protective effect on osteoporotic fractures among current users of thiazide diuretic drugs independent of blood pressure level. This retr
Read ArticleTargeting Autoantibodies in Idiopathic Pulmonary Fibrosis
Idiopathic pulmonary fibrosis carries a high mortality rate and can be a management challenge. Moreover, exacerbations of IPF may be fatal. A multicenter uncontrolled study examined the utility of targeting autoantibody production with revealed surprising results.
Read ArticleFrequency of Infliximab Infusion Reactions
A Canadian registry shows that in community-based infusion clinics, infusion reactions to IFX are uncommon and mild to moderate in nature.
Read ArticleBenefits of Arthroscopic Surgery Questioned
A systematic review of the benefits and harms of arthroscopic knee surgery involving partial meniscectomy for middle-aged and older adults with knee pain and degenerative knee disease was recenttly published in BMJ. They found inconsequential benefits 3-6 months after surgery, but
Read ArticleCommon HIPAA Mistakes in Practice
This review details nine of the most common compliance missteps physicians are making regarding protected health information (PHI). These errors may result in legal trouble, but are avoidable. These include:
Read ArticleDSB: EULAR 2015 Safety Reports
Biologic Use Curtails Sepsis Events. An analysis of the German biologics register, RABBIT, examined the effect of current biologic therapy on future risk of sepsis (#OP0161).
Read ArticleFDA News; Undeclared Dexamethasone Containing OTC Products
The FDA has issued public warnings that 4 over-the-counter products promoted for pain relief contain potentially harmful, undeclared dexamethasone. The supplements are Asihuri Plus Forte, Ginseng She Lian Wan, Jianbu Huqian Wan, and Saurean Fong Sep Lin.
Read ArticleGastroenterologists Use OTC Meds for GERD or Constipation
When gastroenterologists responded to a nationwide survey regarding their management of GERD and contipation, half of the 830 gastroenterology respondents (23% response rate) prescribed for their patients OTC proton-pump inhibitors (PPI), 13% recommended an OTC histamine-2&nbs
Read ArticleThe EULAR 2015 Report – Friday and Saturday
These abstracts and presentations were presented last week on the 12th and 13th of June at the EULAR 2015 annual meeting in Rome.
Read ArticleVaricella Zoster Virus Commonly Found in Giant Cell Artery Biopsies
Varicella-zoster virus infection was studied in temporal artery biopsies from those suspected of having giant cell arteritis.
Read ArticleIncreasing Incidence of Osteomyelitis
A Mayo Clinic analysis of trends in osteomyelitis disclosed 760 new cases between 1969 and 2009 in Olmstead county. Rates increased from 11.4 cases per 100,000 person-years for the period from 1969 to 1979 to 24.4 per 100,000 person-years in the period from 2000 to 2009.
Read ArticleCosmic Etiology to RA and Polymyalgia Rheumatica
Researchers at Johns Hopkins, Mayo Clinic and the NIH have determined that solar cycles and geomagnetic effects may account for the incidence of RA and PMR.
Read ArticleThe Risk of Uveitis in AS Treated with TNF Blockers
Claims data analysis of 2115 ankylosing spondylitis patients without uveitis who started TNF inhibitor therapy revealed that the median time to the onset of uveitis was longest for those taking adalimumab (243 days), followed by etanercept (182 days) and infliximab (144 days). 
Read ArticleExpanding Global Biosimilar Market
Between 2010 and 2013, $95 billion in branded pharmaceutical patents will have expired, leading to significantly higher sales opportunities for those manufacturing generics and biosimilars.
Read ArticleAMA Requests 2-Year Grace Period for ICD-10 Implementation
Physicians at the 2015 AMA Annual Meeting passed policy calling on CMS not to withhold claim payments based on coding errors, mistakes or malfunctions in the system for two years directly following ICD-10 implementation.
Read Article